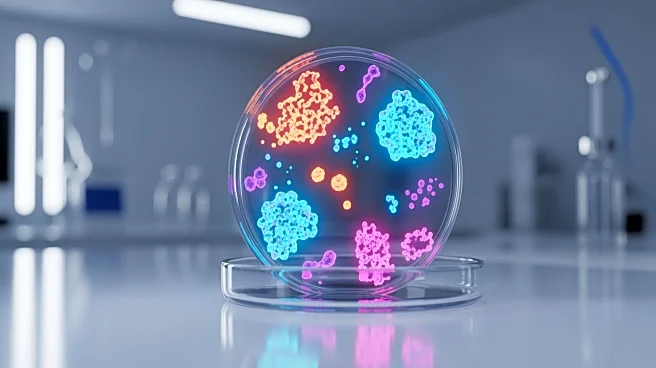
MaaT Pharma Reveals Promising Phase 3 Trial Results for Gut Microbiome Therapy in Cancer Patients

What's Happening?
Michigan State Spartans secured their place in the Sweet 16 of the NCAA Tournament by defeating Louisville with a score of 77-69. The game was marked by a strong performance from Michigan State's Jaxon Kohler, who contributed significantly with a five-point
possession following a Flagrant 1 foul. Coen Carr also played a pivotal role, scoring 21 points and delivering two impressive dunks. Jeremy Fears Jr. broke Magic Johnson's school record for assists in an NCAA Tournament game with 16 assists. Louisville, missing their star guard Mikel Brown Jr. due to injury, struggled to keep pace with Michigan State's aggressive play. The Spartans will face the winner of the UConn-UCLA matchup in the next round.
Why It's Important?
Michigan State's advancement to the Sweet 16 is significant as it marks their 17th trip under coach Tom Izzo, showcasing the team's consistent performance in the NCAA Tournament. This victory not only highlights the team's depth and strategic play but also sets the stage for a potentially challenging matchup in the next round. The Spartans' ability to perform under pressure and adapt to the absence of key players like Louisville's Mikel Brown Jr. demonstrates their resilience and tactical prowess, which could be crucial in their pursuit of further success in the tournament.
What's Next?
Michigan State will prepare to face either UConn or UCLA in the East Region semifinals in Washington, D.C. The team will likely focus on maintaining their momentum and addressing any weaknesses observed in their game against Louisville. Coach Tom Izzo will aim to leverage the team's strengths, such as their effective use of assists and strong defensive plays, to secure a victory in the upcoming matchup. The Spartans will need to strategize against the potential challenges posed by either UConn or UCLA, both of which are formidable opponents.